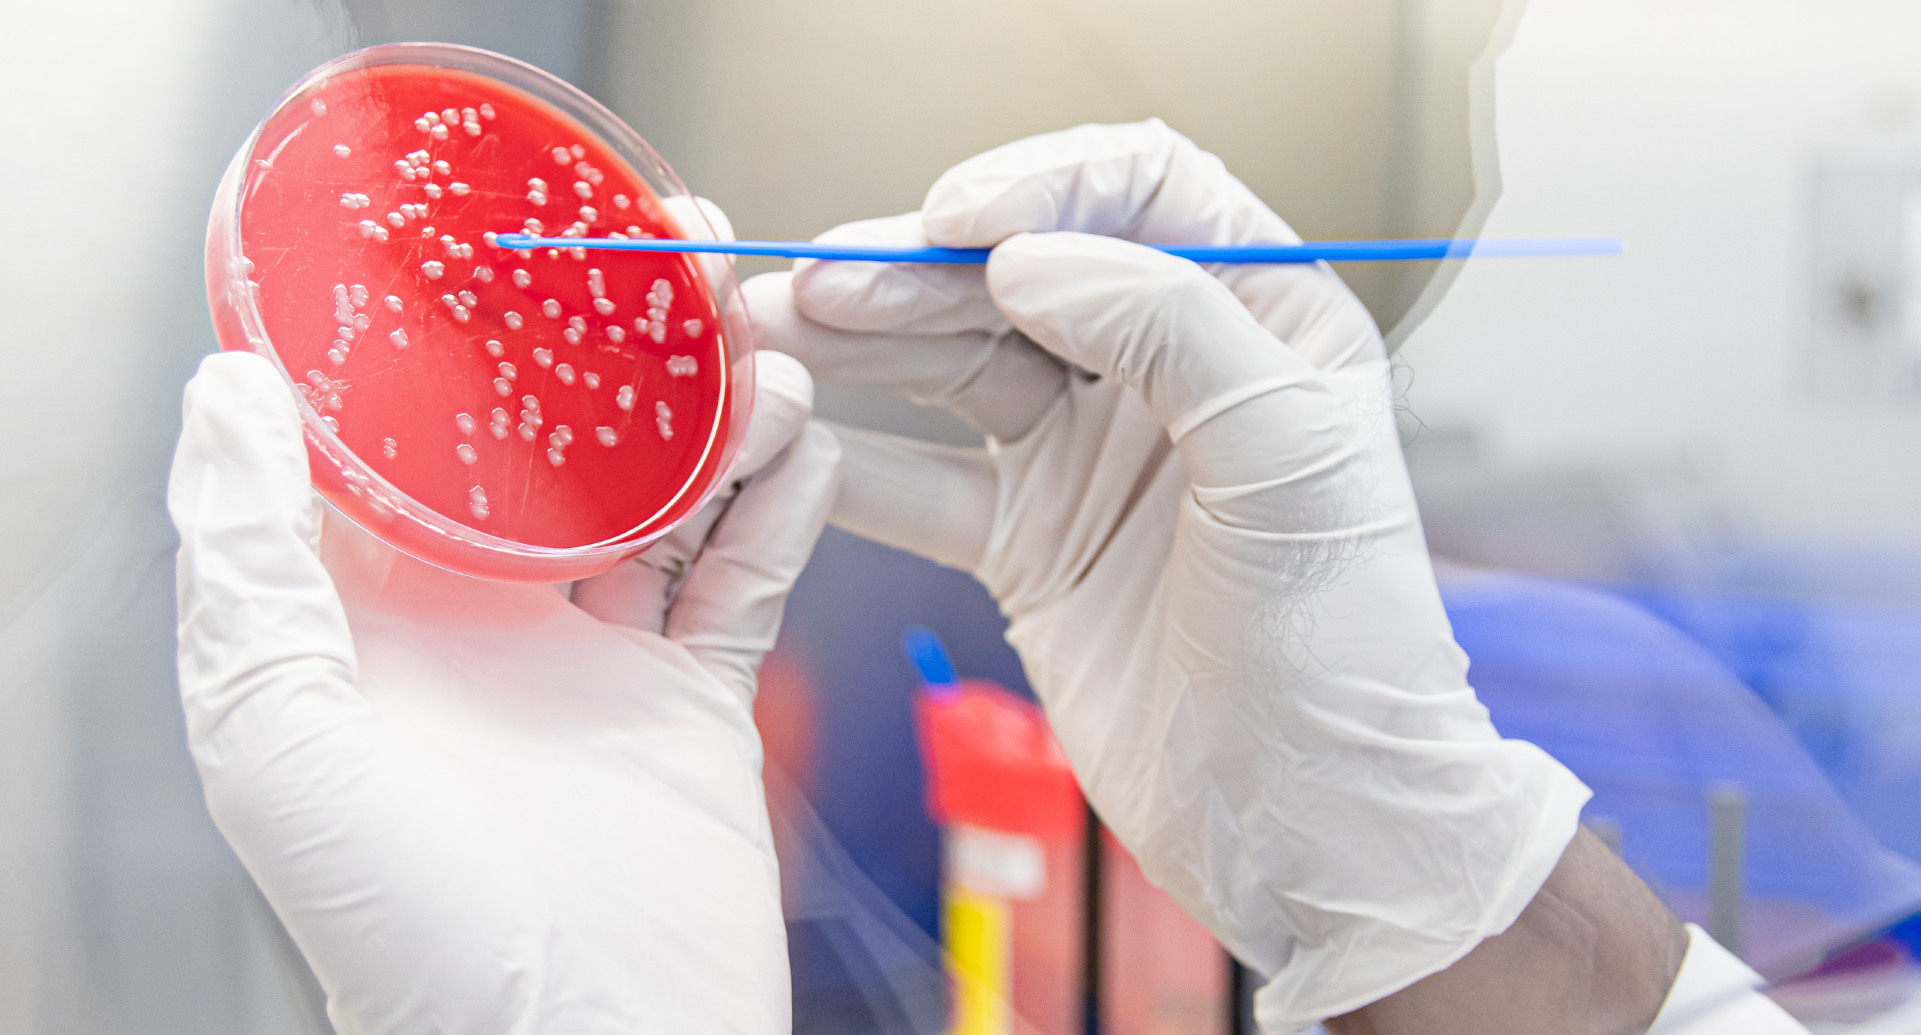
Al Shaqab

يتم توفير خدمات الطب الرياضي وإعادة التأهيل في المركز الطبي البيطري للخيل تحت إشراف أطباء متخصصين مجازين وحائزين على الزمالة، إلى جانب فريق متخصص من الأطباء البيطريين، الأطباء المقيمين، المتدربين الداخليين والممرضين البيطريين.
يمكن أن تؤثر الحالات المختلفة المرتبطة بالصدمات الحادة أو الإصابات المزمنة أو متلازمة الإفراط في التدريب على الخيول الرياضية طوال حياتهم الرياضية وتتمثل أدوار فريق الطب الرياضي وإعادة التأهيل في المركز في التشخيص والوقاية والعلاج من الإصابات أو المشاكل المتعلقة بالرياضة.
ويتم إجراء التشخيصات المتطورة ومعالجة حالات سوء الأداء والعرج بشكل روتيني في قسم خدمات الطب الرياضي في المركز.
كما يتم يومياً تشخيص حالات مثل آلام القدم، ألم المفاصل ، إصابة الأنسجة الرخوة، ألم العظام، آلام الرقبة / الظهر / الحوض.
يُجري فريق الطب الرياضي فحوصات ثابتة وديناميكية مقترنة بتقنيات تسكين الألم التشخيصية (الأعصاب والكتل الزليلية) لتحديد مواضع الألم.
وتتوفر أدوات تصوير عالية الجودة (الأشعة السينية الرقمية والموجات فوق الصوتية) لتقديم رؤية داخلية لبنية الحصان للتوصل إلى التشخيص المناسب وما يترتب عليه من نتائج.
وبالنسبة للحالات التي تحتاج إلى دراسة أعمق ، يوفر المركز أيضًا تقنيات تصوير متقدمة مثل التصوير الومضاني Scintigraphy والتصوير المقطعي CT و التصوير بالرنين المغناطيسي 3T-. ويمكن أيضًا تشخيص تشوهات مشية الخيل بصورة دقيقة ومتابعتها بمساعدة أنظمة تحليل المشية على الحاسوب المتوفرة في المركز.
كما يتم بشكل روتيني تشخيص ضعف الجهاز التنفسي العلوي والسفلي مع / بدون صوت في الجهاز التنفسي والذي يؤدي إلى ضعف في قسم في خدمات الطب الرياضي باستخدام التنظير الاستاتيكي والديناميكي، وكذلك الفحوصات المخبرية المناسبة.
يقدم المركز العلاجات الطبية أو الجراحية المناسبة لتفعيل تعافي/وظيفة المجاري الهوائية. وتتوفر في المركز خدمات تخطيط الصَّدى الدوبلريّ وجهاز ضغط القلب الكهربائي هولتر (مخطط كهربيّة القلب عند الراحة أو التمرين خلال فترات طويلة) للخيول الرياضية التي يشتبه أنها تعاني من مشاكل في القلب والأوعية الدموية.
عادة ما يتم تصميم استراتيجيات علاجية لكل حصان على حدة ويتم دمجها لتحقيق أقصى قدر من العائدات المستدامة على الأداء في أقصر وقت ممكن. ويتم إيلاء اهتمام خاص لأوقات سحب الأدوية من أجل الامتثال لسياسات المنشطات الوطنية والدولية المطبقة في كل نشاط رياضي للخيول.
وتتوفر في المركز الطبي البيطري للخيل مجموعة واسعة من الخيارات العلاجية:
- العلاج المشترك
- العلاج التجديدي لإصابات المفاصل والأوتار / الرباط
- علاج طبيعي قوي لتحفيز إصلاح عالي الجودة للأنسجة
- إستراتيجيات التلبيس لتقويم العظام لمنع الإصابة
- برامج تمارين إعادة التأهيل
العلاج المشترك
أحماض الهيالورونيك ذات اللزوجة العالية ، الكورتيكوستيرويدات (هرمونات منشطة) ذات فعالية ومدة عمل متنوعة ، مواد بولي أكريلاميد الهلامية ، الجليكوزامينوغليكان وغيره.